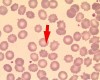
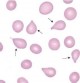

: Acantocitos
: Acantocitos
: Equinocitos
: Equinocitos
 : Esferocitos
: Esferocitos
 : Esquistocitos
: Esquistocitos
 : Codocitos
: Codocitos
 : Queratocitos
: Queratocitos
 : Excentrocitos
: Excentrocitos
 : Eliptocitos
: Eliptocitos
: Dacriocitos
: Dacriocitos
Otros juegos similares:
Otros juegos similares:
Otros juegos similares:




























